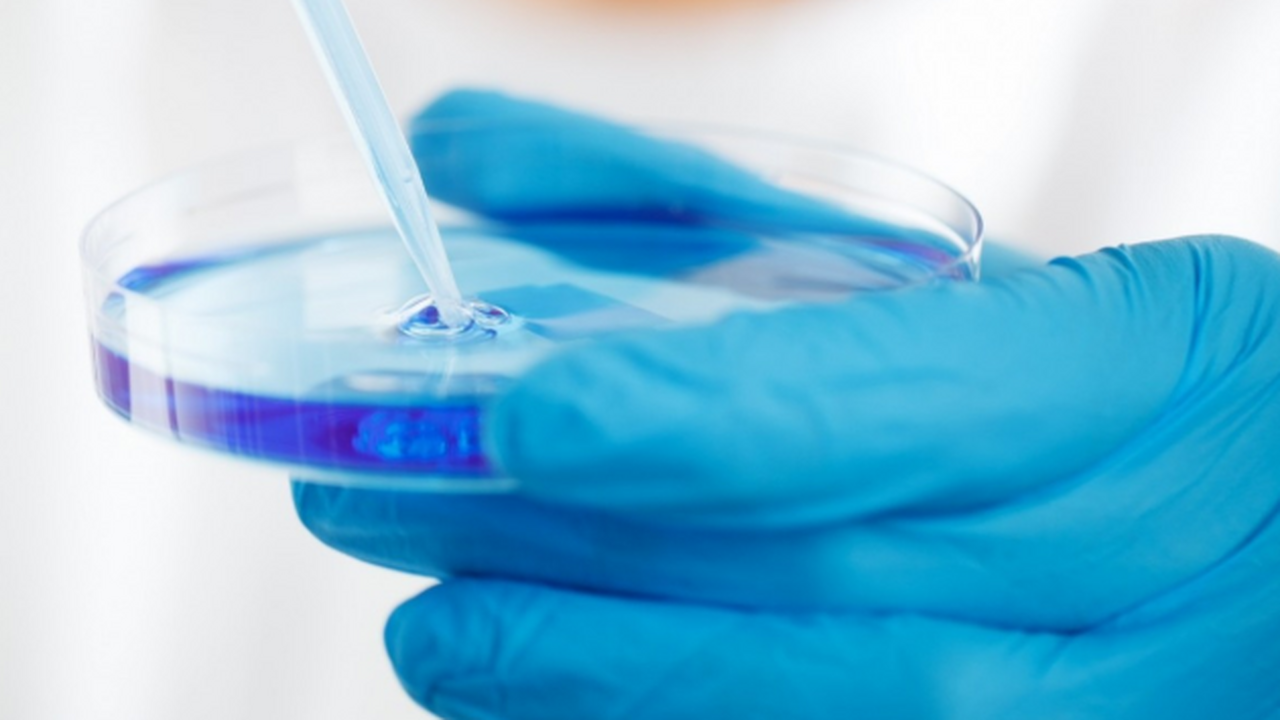
Ученые обнаружили биомаркер в крови, который по...

Новый анализ крови может предупредить о деменции за 25 лет до болезни у женщин
pxhere.com
Исследователи сообщили о важном шаге в изучении деменции. По их данным, специальный анализ крови может заранее показать вероятность развития заболевания у женщин — примерно за 25 лет до появления первых признаков ухудшения памяти.
Ключевым показателем оказался белок p-tau217. Его повышенное содержание связано с процессами, которые происходят в мозге при болезни Альцгеймера. Этот белок участвует в образовании патологических отложений, нарушающих работу нервных клеток.
В исследовании приняли участие более двух с половиной тысяч женщин в возрасте от 65 до 79 лет. На старте наблюдений у них не было признаков когнитивных нарушений. Ученые отслеживали состояние их здоровья на протяжении 25 лет.
Результаты показали, что участницы с повышенным уровнем p-tau217 значительно чаще сталкивались с развитием деменции в более позднем возрасте. Вероятность заболевания у них была примерно в три раза выше по сравнению с остальными участницами.
Также выяснилось, что риск возрастает у носителей генетического варианта APOE-E4 — одного из наиболее известных факторов, связанных с болезнью Альцгеймера.
По словам исследователей, раннее выявление подобных биомаркеров может изменить подход к диагностике деменции. Это позволит начинать наблюдение и профилактику задолго до появления заметных симптомов.
Эксперты считают результаты перспективными, однако отмечают, что для широкого использования такого теста необходимы дополнительные научные подтверждения, сообщает DM.


